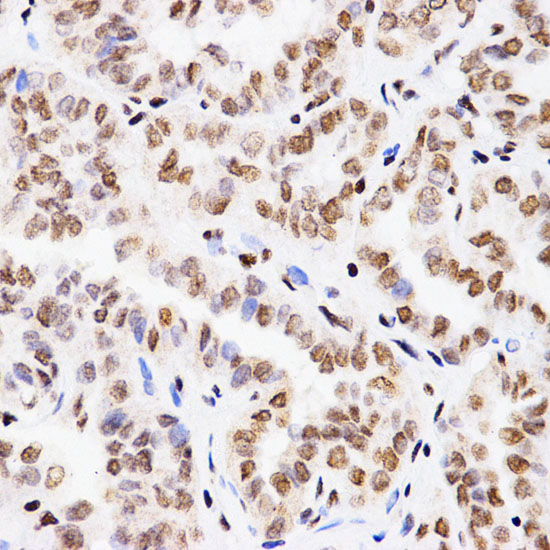

别名:H3K4me; H3 histone; HIST1H3A; Histone cluster 1; H3a应用:WB,IHC,ICC,IP
反应种属:Human,Mouse,Rat
规格:50μl/100μl
| Description |
|---|
| Histones are basic nuclear proteins that are responsible for the nucleosome structure of the chromosomal fiber in eukaryotes. Nucleosomes consist of approximately 146 bp of DNA wrapped around a histone octamer composed of pairs of each of the four core histones (H2A, H2B, H3, and H4). The chromatin fiber is further compacted through the interaction of a linker histone, H1, with the DNA between the nucleosomes to form higher order chromatin structures. This gene is intronless and encodes a member of the histone H3 family. Transcripts from this gene lack polyA tails; instead, they contain a palindromic termination element. This gene is located separately from the other H3 genes that are in the histone gene cluster on chromosome 6p22-p21.3. |
| Specification | |
|---|---|
| Aliases | H3K4me; H3 histone; HIST1H3A; Histone cluster 1; H3a |
| Entrez GeneID | 8290 |
| Swissprot | Q16695 |
| WB Predicted band size | Calculated MW: 16 kDa; Observed MW: 16 kDa |
| Host/Isotype | Rabbit IgG |
| Storage | Store at 4°C short term. Aliquot and store at -20°C long term. Avoid freeze/thaw cycles. |
| Species Reactivity | Human,Mouse,Rat |
| Immunogen | A synthetic methylated peptide corresponding to residues surrounding K4 of human histone H3 |
| Formulation | Liquid in PBS containing 50% glycerol, 0.5% BSA and 0.02% sodium azide, pH 7.3. |
| Application | |
|---|---|
| IP | 1/20 |
| WB | 1/500-1/1000 |
| IHC | 1/50-1/100 |
| ICC | 1/50-1/200 |
![]() |
Western blot analysis of MonoMethyl-Histone H3 (Lys4) in various cell lines lysates using MonoMethyl-Histone H3-K4 antibody. |
![]() |
Chromatin Immunoprecipitation MonoMethyl-Histone H3-K4 pAb Chromatin immunoprecipitation analysis of extracts of 293T cells, using MonoMethyl-Histone H3-K4 antibody and rabbit IgG. P1 and P2 were located on promoter (GAPDH). The amount of immunoprecipitated DNA was checked by quantitative PCR. Histogram was constructed by the rat ios of the immunoprecipitated DNA to the input. |
![]() |
Immunofluorescence analysis of MonoMethyl-Histone H3 (Lys4) in 293T using MonoMethyl-Histone H3-K4 antibody,and DAPI (blue). |
![]() |
Immunohistochemistry analysis of paraffin-embedded rat spleen using MonoMethyl-Histone H3-K4 antibody. High-pressure and temperature Sodium Citrate pH 6.0 was used for antigen retrieval. |
![]() |
Immunohistochemistry analysis of paraffin-embedded Human thyroid cancer using MonoMethyl-Histone H3-K4 antibody.High-pressure and temperature Sodium Citrate pH 6.0 was used for antigen retrieval. |
本公司的所有产品仅用于科学研究或者工业应用等非医疗目的,不可用于人类或动物的临床诊断或治疗,非药用,非食用。
暂无评论
本公司的所有产品仅用于科学研究或者工业应用等非医疗目的,不可用于人类或动物的临床诊断或治疗,非药用,非食用。
中文

发表回复